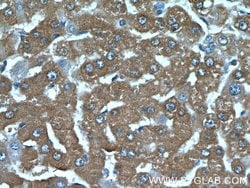
C19orf54 Rabbit anti-Human, Mouse, Polyclonal, Proteintech 20 &mu;L; Unconjugated:Antibodies,

missing translation for 'onlineSavingsMsg'
Learn More
Learn More
C19orf54 Rabbit anti-Human, Mouse, Polyclonal, Proteintech
Rabbit Polyclonal Antibody
Brand: Proteintech 26299-1-AP-20UL
This item is not returnable.
View return policy
Description
The specific function of this protein remains unknown.Specifications
| C19orf54 | |
| Polyclonal | |
| Unconjugated | |
| C19orf54 | |
| C19orf54, UPF0692 protein C19orf54 | |
| Rabbit | |
| Antigen Affinity Chromatography | |
| RUO | |
| 284325 | |
| -20°C | |
| Liquid |
| Western Blot, Immunohistochemistry (Paraffin) | |
| 0.43 mg/mL | |
| PBS with 50% glycerol and 0.1% sodium azide; pH 7.3 | |
| Q5BKX5 | |
| C19orf54 | |
| C19orf54 Fusion Protein Ag23652 | |
| 20 μL | |
| Primary | |
| Mouse, Human | |
| Antibody | |
| IgG |
Product Content Correction
Your input is important to us. Please complete this form to provide feedback related to the content on this product.
Product Title
Spot an opportunity for improvement?Share a Content Correction